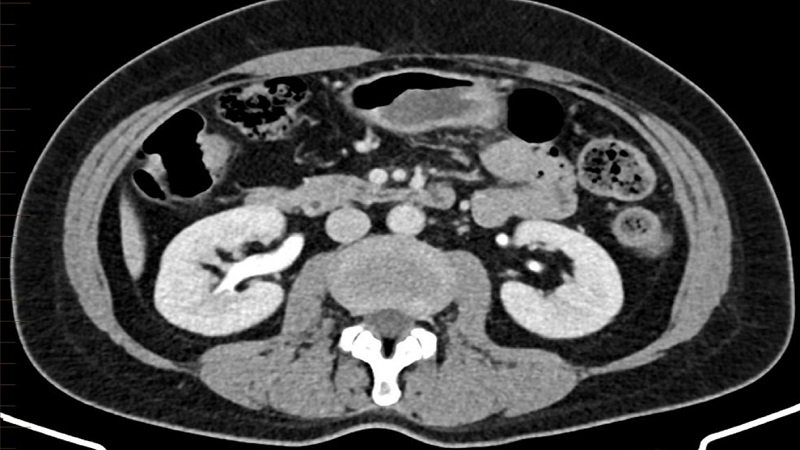
Quy trình chụp CT Scanner hệ tiết niệu chi tiết nhất 1

Tốt nghiệp Khoa Dược trường Đại học Võ Trường Toản. Có nhiều năm kinh nghiệm trong ngành Dược. Hiện đang là giảng viên cho Dược sĩ tại Nhà thuốc Long Châu.
Thị Hằng
11/04/2026
Mặc định
Lớn hơn
Chụp CT Scanner hệ tiết niệu sử dụng tia phóng xạ liều thấp và thuốc cản quang để kiểm tra, đánh giá hiện trạng của các cơ quan bài tiết nước tiểu như: Thận, niệu quản, bàng quang,...
Quy trình chụp CT Scanner hệ tiết niệu được dùng để khảo sát chức năng, cấu trúc của các cơ quan trong hệ bài tiết nước tiểu. Từ đó giúp phát hiện nhanh những bất thường, xác định chính xác bệnh lý đang gặp phải và làm căn cứ để xây dựng liệu pháp can thiệp đích. Trong đó, phương thức xét nghiệm này được xem là lựa chọn tối ưu trong chẩn đoán sỏi niệu quản và sỏi thận.
Chụp CT Scanner hệ tiết niệu còn được biết đến với tên gọi quen thuộc hơn là chụp cắt lớp vi tính hệ tiết niệu. Phương pháp này sử dụng máy chiếu tia X và thuốc cản quang để làm rõ hình thái, đặc điểm cấu tạo và khả năng làm việc của các bộ phận cấu thành nên hệ tiết niệu. Điển hình là niệu quản, thận, bàng quang.
Khi chụp cắt lớp vi tính hệ bài tiết nước tiểu, tia X sẽ quét và tạo ra nhiều lát cắt hình ảnh ở hệ tiết niệu. Tùy vào từng dòng máy mà hình ảnh thu được có thể mô phỏng dạng 2D hoặc 3D. Kỹ thuật này là phương pháp không xâm lấn nhưng vẫn có thể can thiệp sâu và nhận biết chi tiết về khu vực kiểm tra. Đặc biệt nó còn có khả năng đo tỷ trọng, phân biệt rạch ròi các chất có hình thức dễ gây nhầm lẫn như dịch, máu, vôi hóa mô mỡ,...
Ngoài ra, cũng nhờ khả năng nhuộm màu cực hiệu quả của thuốc cản quang mà chuyên viên y tế có thể phân định rạch ròi các cấu trúc, khảo sát tốt hệ mạch máu thận, phát hiện tổn thương trong phạm vi cực nhỏ (1 - 2mm).
Hiện nay chụp cắt lớp vi tính hệ bài tiết nước tiểu được dùng trong nhiều trường hợp: Tầm soát bệnh đường tiết niệu khi kiểm tra sức khỏe định kỳ, chẩn đoán và theo dõi các bệnh lý ở hệ cơ quan này. Tuy nhiên "chỉ định” là khái niệm có ý nghĩa thực hiện kỹ thuật theo đề nghị, khuyến cáo của chuyên gia y tế. Cụ thể, dưới đây là những trường hợp được chỉ định thực hiện xét nghiệm hình ảnh này:

Trong khâu chuẩn bị, trước tiên bác sĩ sẽ tìm hiểu tiền sử bệnh lý, phơi nhiễm phóng xạ và dị ứng của người bệnh. Ngoài ra. chuyên viên y tế còn xem xét qua vấn đề sức khỏe và việc người bệnh có mang thai hay cho con bú hay không.
Căn cứ vào những điều trên và dựa vào mong muốn của người bệnh, bác sĩ sẽ quyết định đình chỉ hay tiếp tục liệu pháp này. Chú ý, tuyệt đối không chụp CT nếu bệnh nhân đang trong tình trạng nguy kịch, suy thận nặng, người bị tim mạch, hen suyễn mạn tính,...
Khi đã loại trừ được các yếu tố nguy cơ và thấy người can thiệp đủ điều kiện để tiến hành xét nghiệm, nhân viên y tế sẽ yêu cầu bạn thực hiện theo các bước sau:

Khi chụp CT, bệnh nhân sẽ lần lượt đi qua các bước sau:
Quy trình chụp CT Scanner hệ tiết niệu thường gói gọn trong chưa đầy 10 phút. Tuy nhiên đây là giá trị trung bình, tùy vào phạm vi khảo sát và thực trạng bệnh lý mà tổng thời gian làm xét nghiệm có thể ngắn hoặc dài hơn.
Sau khi chụp CT hệ bài tiết nước tiểu, nếu người bệnh không dùng thuốc cản quang (ít phổ biến) thì không cần phải nghỉ dưỡng mà có thể ăn uống, sinh hoạt như bình thường. Đối với trường hợp tiêm thuốc cản quang thì người thực hiện cần ở lại cơ sở y tế tối thiểu 30 phút để theo dõi sức khỏe, đề phòng những biến chứng có thể xảy ra. Đặc biệt đừng quên uống thật nhiều nước trong vòng 24 giờ kể từ thời điểm chụp CT để đào thải sạch lượng thuốc cản quang đã dung nạp vào cơ thể.
Trong thời gian theo dõi sức khỏe, nếu người can thiệp xuất hiện dấu hiệu bất thường như phát ban, tiêu chảy, khó thở, xây xẩm, đau đầu,... thì cần báo ngay cho nhân viên y tế để được hỗ trợ kịp thời.
Kết quả chụp CT Scanner hệ tiết niệu thường được trả sau 30 - 40 phút. Sau đó bác sĩ sẽ trao đổi với người bệnh về kết quả thu được cũng như đưa ra những chẩn đoán ban đầu. Trong trường hợp có dấu hiệu nghi ngờ nhưng không rõ ràng thì hình ảnh chụp CT sẽ được hội chẩn trước khi giới chuyên môn đưa ra kết luận cuối cùng.

Trên đây là quy trình chụp CT Scanner hệ tiết niệu được tổng hợp từ các tài liệu y khoa uy tín. Cảm ơn bạn vì đã tham khảo thông tin sức khỏe từ Nhà thuốc Long Châu và hãy theo dõi thường xuyên để có thêm nhiều kiến thức bổ ích nhé!
Xem thêm: Chụp CT 128 dãy: Ứng dụng, ưu nhược điểm và một số lưu ý
Dược sĩ Đại họcTừ Vĩnh Khánh Tường
Tốt nghiệp Khoa Dược trường Đại học Võ Trường Toản. Có nhiều năm kinh nghiệm trong ngành Dược. Hiện đang là giảng viên cho Dược sĩ tại Nhà thuốc Long Châu.